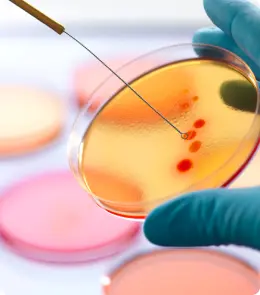

About Rapid Test LAboratories
YOUR PARTNER IN EXCELLENCE

Rapid Test Laboratories is a full-service independent clinical laboratory that manages the entire patient lab testing experience, from scheduling with customer support to collection, transport, processing, and results. What sets us apart from other laboratories are our all-in-one custom-tailored solutions allowing us to be flexible and provide swift turnaround times. This results in reduced financial and administrative burdens so facilities can focus on what they do best: patient care.

We take great pride in serving local neighborhoods with a warm and friendly lab experience. Our trusted lab technicians are well-trained, and our lab processes are second to none, leaving you with the confidence you are in the care of true professionals.

In our never-ending quest to help patients, our goal is to help you take better control of your health through Antibiotic Stewardship, Long Term Care, Skilled Nursing, Assisted Living, Memory Care, Hospice Services, Home Health Phlebotomy Draws, Mobile Phlebotomy Fleets and Courier Network, Employer Health and Wellness as well as, County, State and Federal Laboratory Contracting.